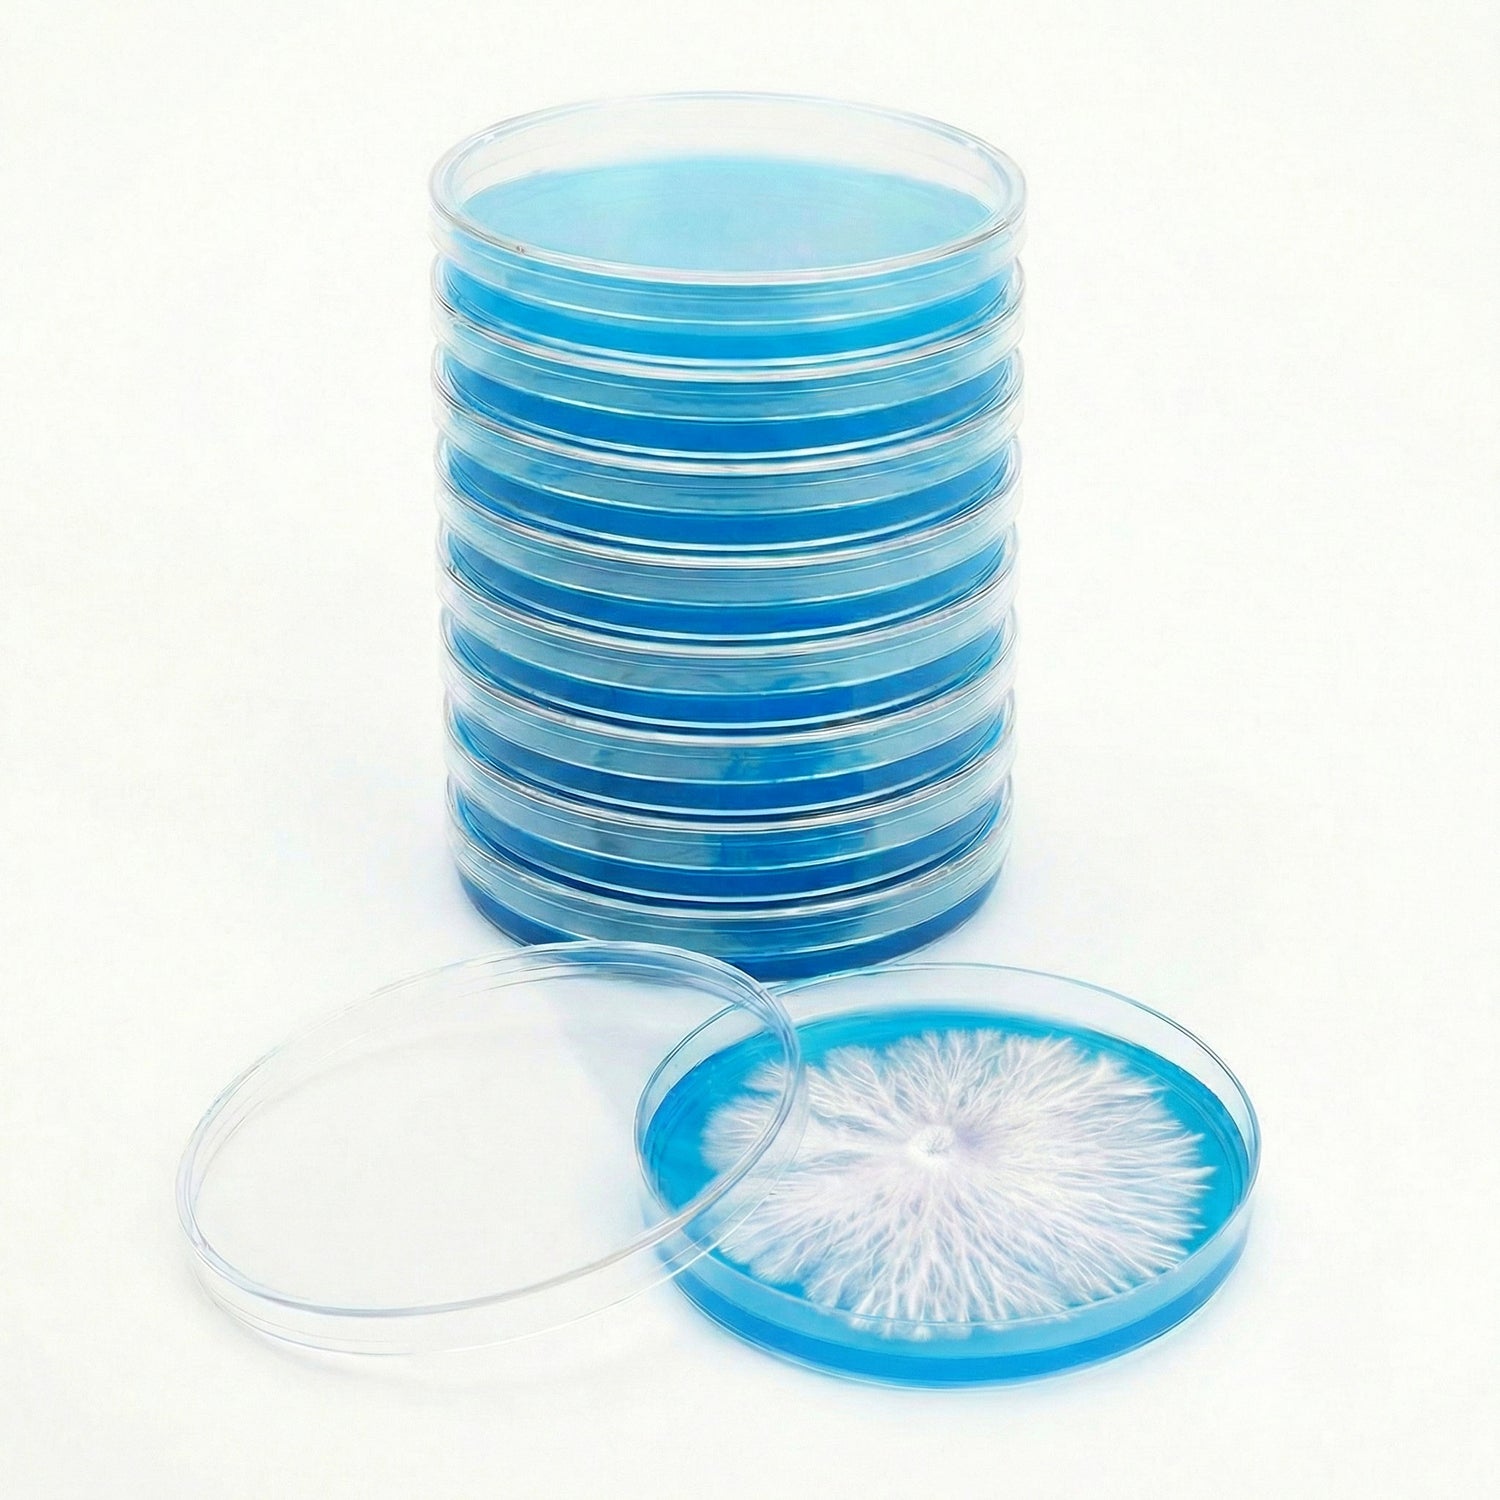
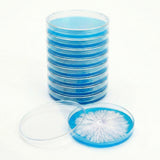
stack of 10 agar plates with rhizomorphic mycelium growing

Rapid Rhizo Pre-Poured Sterilized Agar Plates (10-Pack)
Rapid Rhizo Pre-Poured Sterilized Agar Plates (10-Pack) is backordered and will ship as soon as it is back in stock.
Couldn't load pickup availability
Description
Description
Rapid Rhizo Pre-Poured Sterilized Agar Plates (10-Pack)
Now in a 10-Pack · Freshly Poured Daily · Made for Aggressive Rhizomorphic Growth
360° view: see the rhizomorphic style growth, fill level, and finish of each pre-poured plate.
Level up your mycology work with our Rapid Rhizo Agar Plates in a convenient 10-pack. These pre-poured plates use a custom nutrient + yeast blend that encourages fast, aggressive rhizomorphic mycelium—making it easier to isolate your strongest genetics and capture clean, photogenic transfers.
Unlike agar that sits on shelves for weeks, our plates are poured fresh and sealed in protective packaging to help preserve moisture and performance. Whether you're cleaning cultures, transferring isolates, or showcasing final sectors, Rapid Rhizo provides the aggressive edge experienced cultivators look for.
What’s Included
- 10 Rapid Rhizo Agar Plates – 90mm polystyrene Petri dishes
- Pre-poured & ready-to-use – no mixing, sterilizing, or pouring
- Fresh production – made for consistent performance and strong growth
Key Features
- Promotes Rhizomorphic Growth – excellent for 2nd/3rd transfers and “showcase” plates
- Pressure Sterilized & Poured under clean workflow conditions
- Chloramphenicol added to help suppress common bacterial contamination*
- Consistent fill – machine-dispensed 25ml per plate
- Storage – refrigerate and use within 3–4 weeks for best results
*Antibiotics can help reduce certain bacteria but do not replace sterile technique.
Machine-Poured Precision You Can Trust
All plates are produced in a controlled workflow using automated prep + dispensing systems for repeatable results. Each batch is:
- Blended and sterilized at 18 PSI for 30 minutes
- Cooled and dispensed with exact 25ml pours
- UV-C treated, capped, and labeled for consistency
Which Agar Plate Should I Choose?
Different agar recipes are useful at different stages—spore germination, contamination checks, clean transfers, and “final” display plates. Here’s a quick guide to match the plate to your goal.
| Agar Type | Best For | Why Growers Use It | Recommended Stage |
|---|---|---|---|
| Rapid Rhizo (This Listing) | 2nd & 3rd transfers, clean isolation, showcase plates | Encourages aggressive, threadlike growth patterns that are easy to select and preserve | After first clean-up → final transfers |
| Regular LME / MEA | Spore germination, first plates, contamination checks | A reliable “baseline” nutrition profile that makes early growth and contamination easier to evaluate | Start here (spores/tissue) → first transfer |
| Black MEA | High visibility growth, photo-friendly plates, subtle sector spotting | Dark background increases contrast so mycelium edges, sectors, and early contaminants stand out | Any stage (especially when evaluating detail) |
| Manure-Enriched / “Conditioning” Agar | Preparing cultures for bulk substrates, performance testing | Helps “condition” cultures to richer environments and evaluate how genetics behave on supplemented media | Mid-to-late stage (after clean culture) |
Rapid Rhizo (This Listing)
Regular LME / MEA
Black MEA
Manure-Enriched / Conditioning Agar
Tip: Many growers start spores on LME/MEA, clean up on early transfers, then finish on Rapid Rhizo (or use Black MEA when visibility matters).
What Is Agar and How Do I Use These Plates?
Agar is the foundation of clean culture work. Place a tiny amount of spore solution, tissue, or culture onto the plate and incubate. Within days, mycelium spreads across the surface—letting you isolate clean growth away from contamination.
- Spore to agar: start genetics and identify contaminants early
- Transfers: isolate clean sectors and refine growth
- Final plates: preserve your best genetics for grain jars, spawn bags, or liquid culture
See Our Agar Lab & How Plates Are Made
Watch our pouring system and lab workflow in action—from sterile prep to precise machine fills—so you know exactly what you’re getting.
Behind the scenes: our agar prep + pouring workflow for consistent, clean plates.